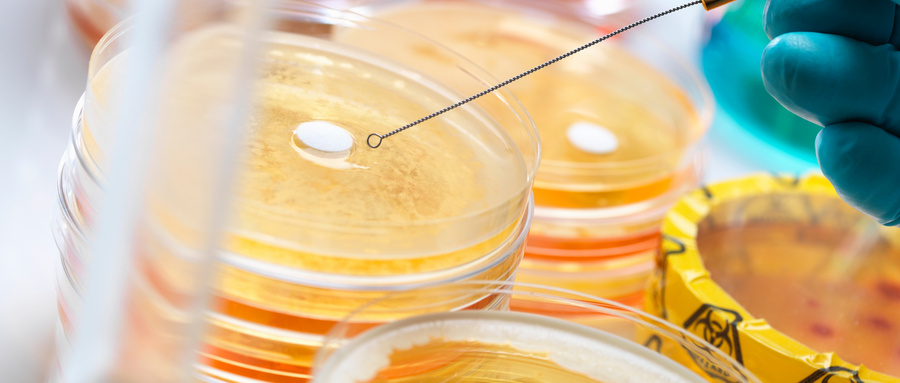

??

在第三期的植物精油的多種生理活性及其應(yīng)用中,我們向大家介紹了精油的驅(qū)蟲殺蟲活性。本期文章我們繼續(xù)探討植物精油的抑菌抗菌活性。(往期回顧:《NAGO SHARE ▏植物精油的多種生理活性及其應(yīng)用(3)》)

(植物精油系列3)
抑菌抗菌中的“菌”既包括細(xì)菌也包括真菌,它們都屬于微生物。微生物可以說無(wú)處不在,在空氣中,泥土中,江河中,甚至生物體中都普遍存在。雖然我們?nèi)庋劭床灰?,它們卻與我們的生存和生活緊密相關(guān)。比如人體內(nèi)的細(xì)菌主要存在于腸道,與自身細(xì)胞的比例約為1:1,數(shù)量達(dá)到10萬(wàn)億級(jí)別??梢娢覀兣c微生物的聯(lián)系程度之深。
?大量細(xì)菌在人體內(nèi)存活是生命進(jìn)化的結(jié)果。人體內(nèi)的細(xì)菌雖多,但在正常情況下,它們與人體和諧相處,我們稱它們?yōu)橛幸嫖⑸?。此外,酸奶、醋、醬油等我們生活常見的食物,也離不開乳酸桿菌、醋酸桿菌和一些曲霉菌的發(fā)酵。
但大自然中也存在著許多致病菌。它們?cè)斐稍S多人類常見疾病和多發(fā)病,也是食品污染的主要危險(xiǎn)因素,如沙門氏菌、大腸桿菌、金黃色葡萄球菌、白色假絲酵母等。沙門氏菌是一種常見的食源性致病菌和人畜共患病病原菌,能夠引起傷寒、急性腸胃炎、敗血癥等多種疾病。部分大腸桿菌在一定條件下引起疾病,如能夠引起人體或動(dòng)物胃腸道感染、尿道感染以及敗血型感染等。微生物還會(huì)感染植物,降低糧食產(chǎn)量,赤霉病是小麥容易感染的病菌之一 ,擔(dān)子類立枯絲核菌引發(fā)的水稻紋枯病是危害最為嚴(yán)重的水稻真菌病害之一,玉米彎孢菌葉斑病是我國(guó)玉米生產(chǎn)上重要的葉部病害,作物一旦感染上這幾種病菌,就會(huì)導(dǎo)致產(chǎn)量和品質(zhì)下降。

精油抗菌
從1929年,世界上第一種抗生素——青霉素被發(fā)現(xiàn)以來(lái),抗生素在抗菌殺菌的高效性能使得抗生素在各領(lǐng)域得到廣泛的應(yīng)用。但是抗生素的濫用很快使得微生物產(chǎn)生耐藥性,并可能導(dǎo)致人體內(nèi)菌群失調(diào),對(duì)抗生素敏感的微生物被殺死,而不敏感的微生物趁機(jī)大量繁殖,造成二次感染。人工合成的抗菌抑菌物質(zhì)也越來(lái)越多地引起人們關(guān)于安全性的不安情緒。

進(jìn)入21世紀(jì),人們?cè)谶x擇上越來(lái)越趨于綠色環(huán)保,追求自然。植物精油提取于植物,來(lái)源于自然,經(jīng)過漫長(zhǎng)的自然演化,在大自然已經(jīng)具有完整的循環(huán)降解途徑,因此,使用植物精油抗菌抑菌是一種對(duì)生態(tài)環(huán)境友好的方式。
此外,植物精油毒性小,能保障生物體的健康安全。并且精油成分復(fù)雜,含有幾十、上百種物質(zhì),因此植物精油抗菌抑菌的作用機(jī)理復(fù)雜,通常具有多位靶點(diǎn),數(shù)種成分協(xié)同作用,微生物難以產(chǎn)生抗性,同時(shí),也降低了單種成分的用量。
殺菌抗菌的機(jī)理
精油成分復(fù)雜多樣,主要含有萜類化合物、芳香族化合物、脂肪族化合物以及含氮含硫類化合物等各類化學(xué)物質(zhì)。各成分的化學(xué)結(jié)構(gòu)不同,抑菌機(jī)理也存在巨大差異。以下簡(jiǎn)單介紹植物精油的幾種常見的抑菌機(jī)理。
對(duì)微生物細(xì)胞壁的作用
細(xì)胞壁是細(xì)胞的保護(hù)屏障,能維持細(xì)胞的生理形態(tài),并降低細(xì)胞對(duì)胞外物質(zhì)的敏感性。而細(xì)胞壁的主要構(gòu)成成分和與細(xì)胞壁有關(guān)的酶可作為精油活性成分的重要作用位點(diǎn),從而影響細(xì)胞壁的正常生理功能。酚類物質(zhì)可影響細(xì)胞壁的功能,導(dǎo)致細(xì)胞因缺少保護(hù)組織而衰亡;α-松油烯能影響與細(xì)胞壁結(jié)構(gòu)和功能有關(guān)的基因?qū)е箩劸平湍傅牡挚沽ο陆?,促進(jìn)了精油的抗菌效果。檸檬醛能損傷細(xì)胞壁上的功能脂質(zhì)蛋白,導(dǎo)致膜對(duì)營(yíng)養(yǎng)物質(zhì)的吸收轉(zhuǎn)運(yùn)率顯著下降。

對(duì)微生物細(xì)胞膜的作用
精油破壞細(xì)胞膜脂質(zhì)層的雙層膜結(jié)構(gòu),從而增大細(xì)胞膜的通透性,導(dǎo)致細(xì)胞內(nèi)重要離子或物質(zhì)流出,引起細(xì)胞死亡。段雪娟等研究發(fā)現(xiàn)肉桂精油能破壞或溶解金黃色葡萄球菌的細(xì)胞膜,在電子顯微鏡下觀察到細(xì)胞萎縮,并檢測(cè)到電導(dǎo)率增加,從而表明胞內(nèi)鈉離子、鉀離子等內(nèi)容物的外泄。ULTEE等研究發(fā)現(xiàn)香芹酚由于其較好的脂溶性可在細(xì)胞質(zhì)膜中積累,引起細(xì)胞膜擴(kuò)張,并導(dǎo)致膜不穩(wěn)定及離子泄露。

對(duì)呼吸系統(tǒng)和能量代謝的作用
精油進(jìn)入細(xì)胞內(nèi)部,破壞菌體線粒體膜,影響細(xì)胞的能量代謝,最終導(dǎo)致細(xì)胞死亡。當(dāng)糖的氧化分解過程受到抑制,阻礙細(xì)胞正常供能,使細(xì)胞功能受損,甚至導(dǎo)致生物體死亡。抑菌物質(zhì)能通過阻止微生物對(duì)葡萄糖的吸收和利用,阻止能量的供應(yīng),致使微生物細(xì)胞生長(zhǎng)和繁殖受阻,從而達(dá)到抗活性的效果。ULTEE等研究發(fā)現(xiàn)香芹酚通過將其羥基質(zhì)子交換為另一種離子(鉀離子等)而充當(dāng)單價(jià)陽(yáng)離子的跨膜載體,使質(zhì)子釋放到細(xì)胞質(zhì)內(nèi)而降低質(zhì)子動(dòng)力,影響ATP的合成而導(dǎo)致細(xì)胞死亡。李金寒等研究發(fā)現(xiàn)檸檬醛能刺激黃曲霉產(chǎn)生活性氧自由基,并在細(xì)胞內(nèi)蓄積,活性氧自由基對(duì)生物大分子產(chǎn)生不可逆的氧化損傷。

對(duì)細(xì)胞核酸和蛋白質(zhì)的影響
核酸是微生物重要的遺傳物質(zhì),蛋白質(zhì)是生命的物質(zhì)基礎(chǔ)。影響核酸的正常轉(zhuǎn)錄、編碼導(dǎo)致蛋白質(zhì)合成量減少,尤其是對(duì)結(jié)構(gòu)蛋白、催化蛋白的合成進(jìn)行抑制,使菌體正常功能遭到破壞,達(dá)到抑菌抗菌的效果。羅曼研究發(fā)現(xiàn)檸檬醛可以使菌絲體DNA、RNA、脂類和蛋白質(zhì)等的生物合成受到抑制,進(jìn)而影響相關(guān)基因的表達(dá)與調(diào)控,擾亂能量代謝與遺傳穩(wěn)定性,最終導(dǎo)致細(xì)胞死亡。李亞茹等研究發(fā)現(xiàn)萜烯類成分能夠降低細(xì)胞內(nèi)氧化反應(yīng)的水平,從而影響核酸修復(fù)。

小結(jié)
經(jīng)過研究人員們的大量研究測(cè)試,結(jié)果證明許多植物精油有著不同程度的抗菌抑菌性能,部分精油也已經(jīng)實(shí)際應(yīng)用于各領(lǐng)域的微生物控制方面。在綠色環(huán)保的時(shí)代趨勢(shì)下,精油抗菌抑菌有著廣闊的應(yīng)用空間。但是精油抗菌抑菌要得到廣泛應(yīng)用仍需克服一定的困難。植物精油成分復(fù)雜,對(duì)微生物有多位靶點(diǎn)的特性讓微生物不容易出現(xiàn)抗性的同時(shí),也讓精油在質(zhì)量控制、穩(wěn)定性、配伍性上仍存在不少問題。這需要相關(guān)行業(yè)、相關(guān)研究人員進(jìn)行更深入的探究。在本章節(jié),我們簡(jiǎn)單介紹了抗菌抑菌的必要性,以及論述了植物精油作為抗菌抑菌劑的機(jī)理研究。在下一部分,我們將圍繞植物精油在目前各領(lǐng)域的應(yīng)用情況展開論述。
參考文獻(xiàn)
[1]翟秀超,馮文旭,吳殿輝,王璐,陸健. 植物精油對(duì)真菌微生物抑制作用的研究進(jìn)展[J]. 食品與發(fā)酵工業(yè),2021,47(06):259-266+279.
[2]劉德贊,李文茹,謝小保.植物精油的抗菌性能及其應(yīng)用研究進(jìn)展[J].工業(yè)微生物,2021,51(05):53-57.
[3]劉歡,肖苗,賀小賢,王意,曹娟娟,蔣合陽(yáng),李瑩玉,蘆平.植物精油對(duì)病原微生物抑菌作用和機(jī)制的研究進(jìn)展[J].食品與發(fā)酵工業(yè),2021,47(16):278-282.
[4]Ultee A , Bennik M H J , Moezelaar R . The Phenolic Hydroxyl Group of Carvacrol Is Essential for Action against the Food-Borne Pathogen Bacillus cereus[J]. Applied and Environmental Microbiology, 2002, 68(4):1561-1568.
[5]羅曼. 天然抗菌香精油篩選及主要抗菌成分研究[D]. 武漢大學(xué), 2004.
[6]段雪娟, 韓雅莉, 劉澤璇,等. 肉桂精油氣相熏蒸金黃色葡萄球菌的抗菌機(jī)理[J]. 現(xiàn)代食品科技, 2021.
[7]李金寒, 商博, 梁丹丹,等. 活性氧在檸檬醛抑制黃曲霉產(chǎn)毒過程中的作用[J]. 核農(nóng)學(xué)報(bào), 2016(7):7.
[8] Ron S , Shai F , Ron M . Revised Estimates for the Number of Human and Bacteria Cells in the Body[J]. Plos Biology, 2016, 14(8):e1002533-.
[9]李亞茹, 周林燕, 李淑榮,等. 植物精油對(duì)果蔬中微生物的抑菌效果及作用機(jī)理研究進(jìn)展[J]. 食品科學(xué), 2014(11):5.

復(fù)制